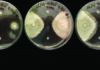
Comprendre la résistance aux fongicides

Minimal sampling of soil moisture on hybrid sports fields with POGO Mini sensor
                    Introduction 
“Precision greenkeeping” requires usage of complex technological decision support tools to help greenkeepers or intendants. Soil moisture sensors are part of this tool panel for proper irrigation practices.
In practice, intendants make soil moisture measurements on a regular basis...                
                
            A propos
                    
Pourquoi la clinique du gazon ?
Après 11 années d'expérience dans la recherche et le développement de produits pour l'entretien des gazons, j'ai décidé de créer ce site web dont le but est de fournir aux intendants des informations précises...